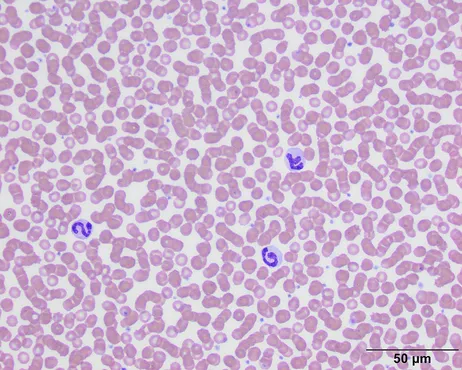
Blood

Blood testing is done for many reasons such as sick or emergency situations, preanesthetic testing, preventative care screening, and medication monitoring. Testing gives us incredible insights on the health status of your pet. There are many components of the tests that are performed. The most common tests are a complete blood count (CBC), chemistry profile, urinalysis and thyroid.
Complete Blood Count (CBC)
A CBC is a blood tests that analyzes the size and quantity of different blood cells and evaluates different components of the blood.
* Red Blood Cells, which carry oxygen
* White blood Cells, which fight infection
* Hemoglobin, the oxygen-carrying protein in red blood cells
* Hematocrit, the amount of red blood cells in the blood
* Platelets, which help blood to clot
These parameters are used to screen for these conditions:
- Anemia
- Inflammation
- Infection
- Stress
- Leukemia
- Bleeding disorders
- Inability to fight infection
- Hydration status
Chemistry Profile
A chemistry profile is a blood test that measures the amount of electrolytes, fats, proteins, sugar, and enzymes. These tests give very important information about how well your pet's kidneys, liver, and pancreas are functioning and assesses electrolyte balance.
These parameters are used to screen for these conditions:
- Renal disease
- Infection
- Kidney stones
- Cancer
- Abnormalities resulting from long-term medications
- Liver disease
- Cushing's disease
- Dehydration
- Bile duct obstruction
- Pancreatitis
- Diabetes
Urinalysis
A urinalysis is a test of the urine. It's used to detect and manage a wide range of disorders. It is essential for a comprehensive evaluation of kidney function.
This test is used to help detect:
- Diabetes
- Chronic kidney disease
- Kidney or bladder stones
- Bacterial infections
Thyroid
The thyroid gland produces a hormone called Thyroxine (T4) which is essential for growth and metabolism. It controls how your body uses energy.
This test is used to determine:
- Hypothyroidism (Not enough hormone)
- Hyperthyroidism (Too much hormone)



